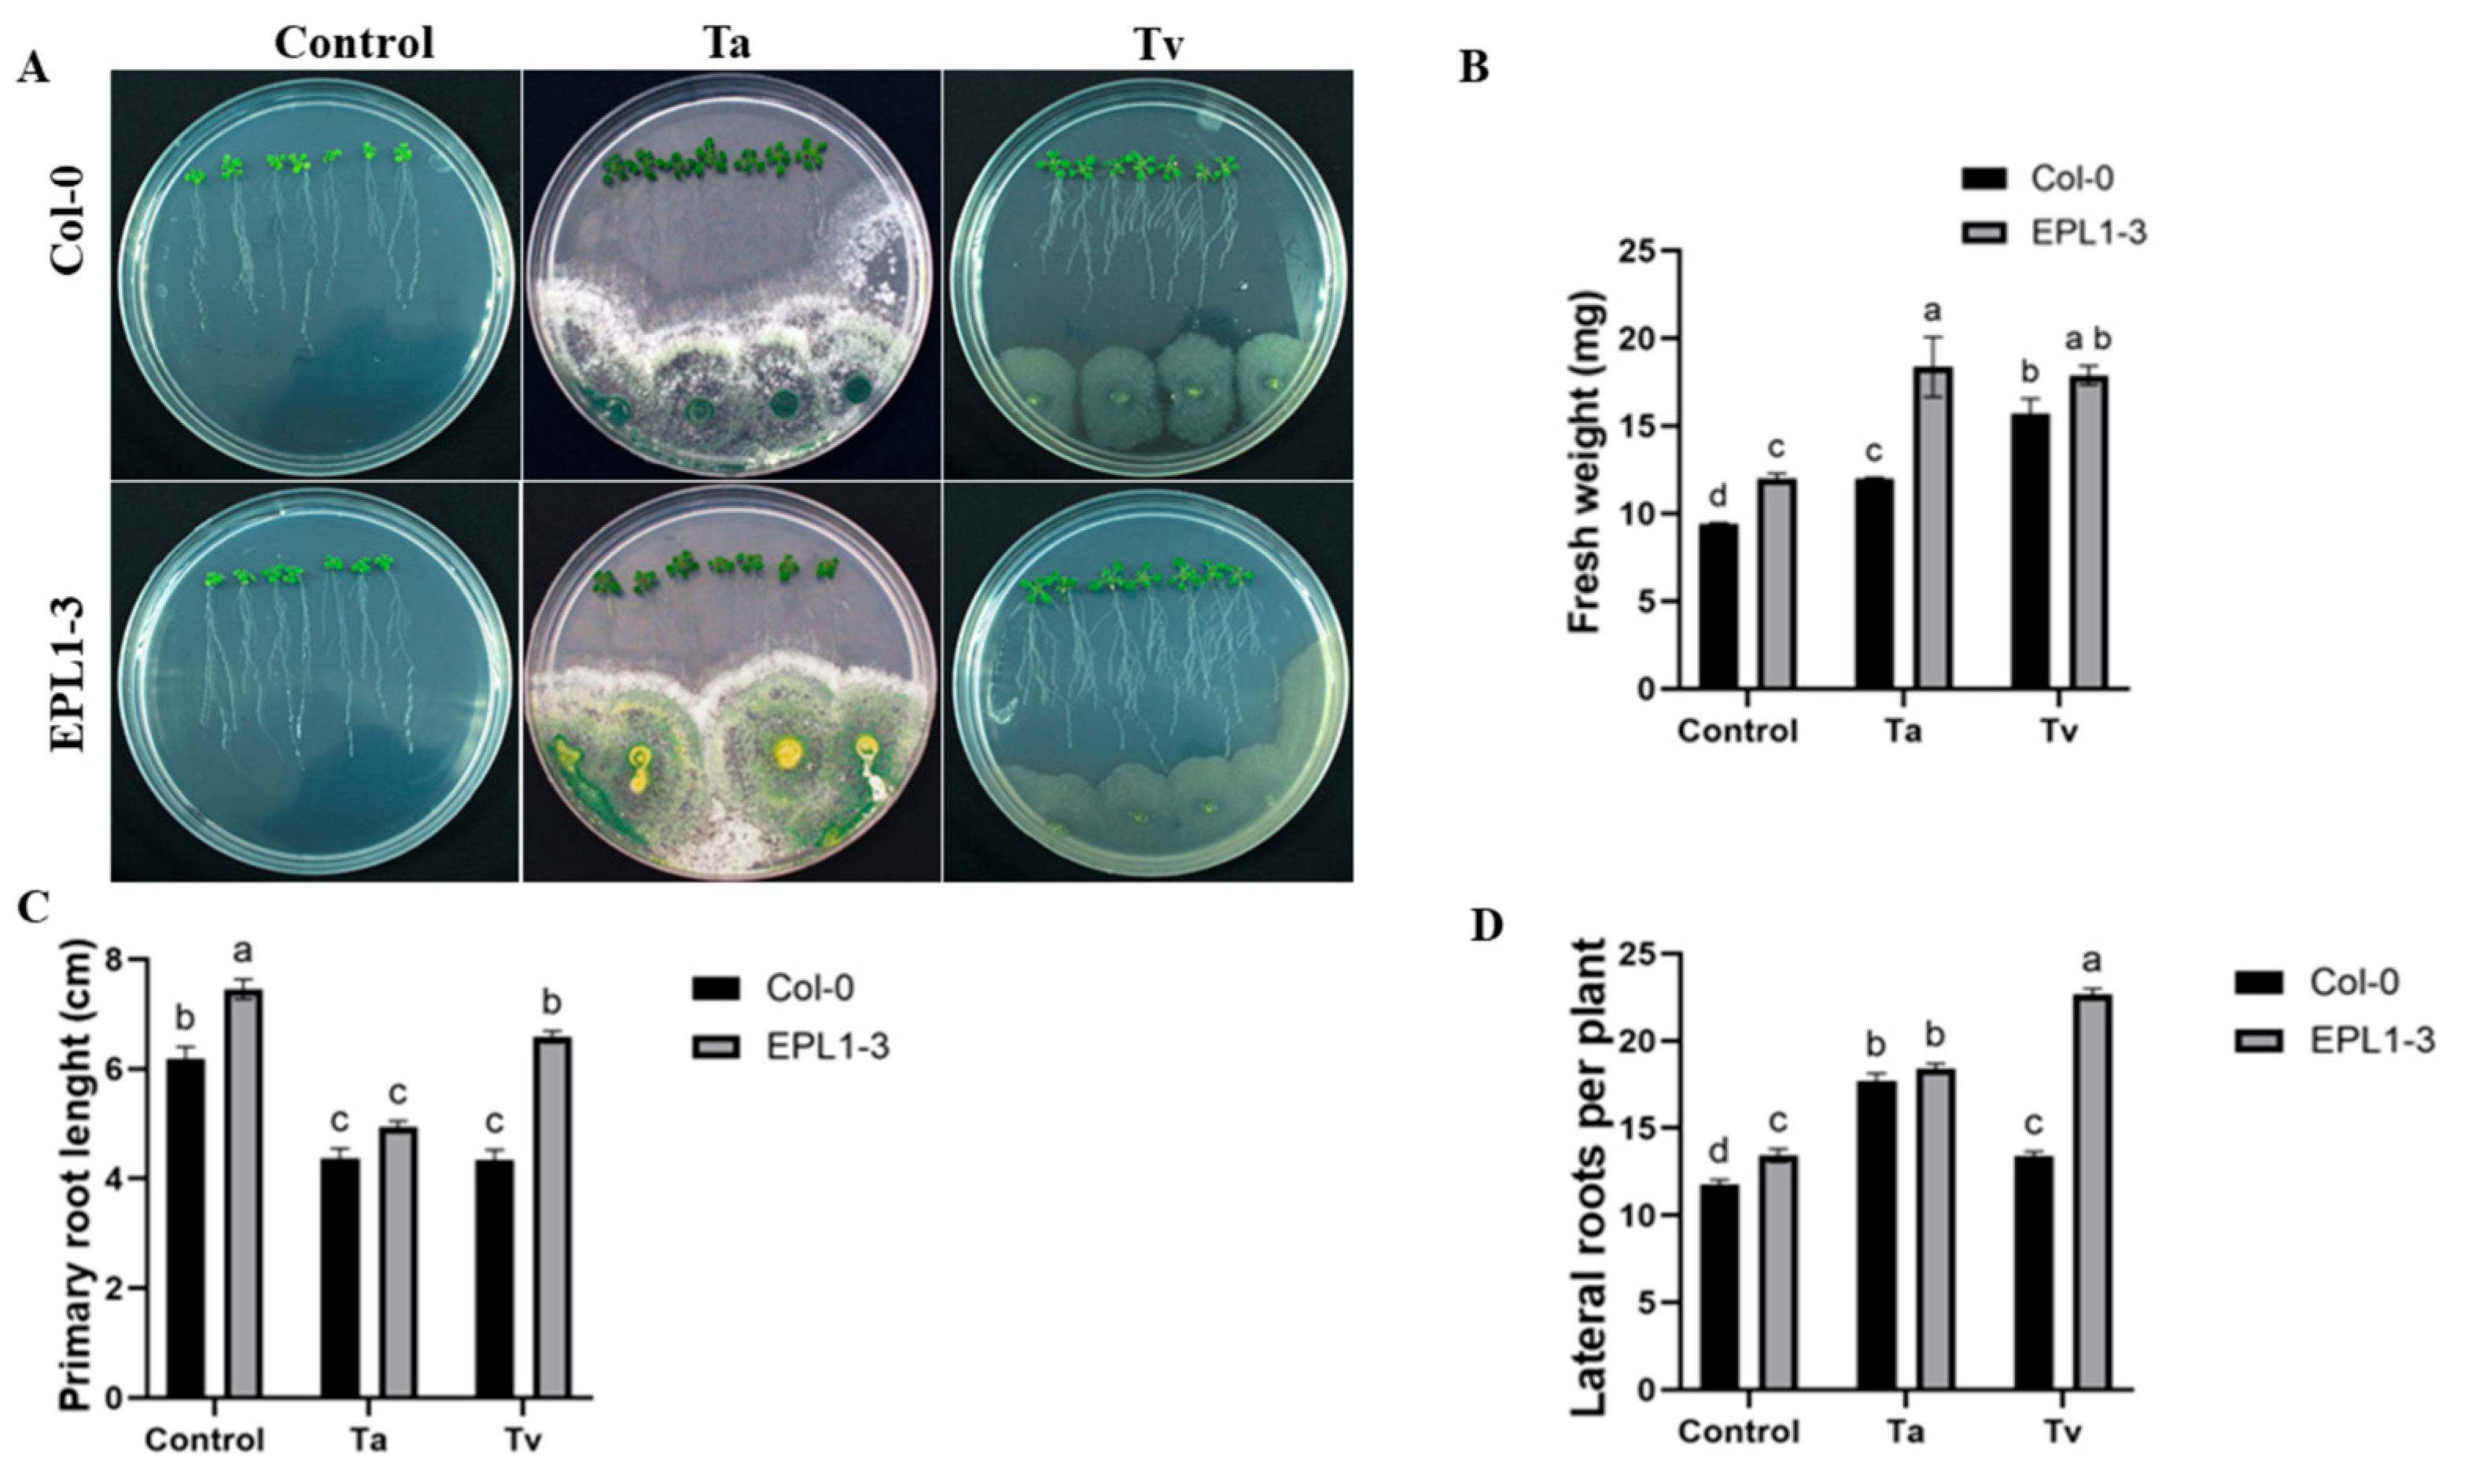
Plants 14 02794 g001

Inoculation with Trichoderma atroviride and T. virens Induces ROS Overaccumulation and Compromises Pathogen Resistance in Arabidopsis 35S::TaEPL1-3 Plants
Abstract
1. Introduction
2. Results
2.1. Effect of T. atroviride and T. virens Inoculation on the Growth of 35S::TaEPL1-3 Plantlets Grown In Vitro
2.2. The Arabidopsis 35S::TaEPL1-3 Line Exhibits Reduced Resistance to Pseudomonas syringae When Co-Inoculated with Trichoderma Species
2.3. Co-Inoculation with Trichoderma Species Also Compromises the Resistance of the Arabidopsis 35S::TaEPL1-3 Line to Botrytis cinerea
2.4. Trichoderma Co-Inoculation in the 35S::TaEPL1-3 Line Induces Increased Hydrogen Peroxide (H2O2) Accumulation
2.5. Hydrogen Peroxide Content in the 35S::TaEPL1-3 Line Following Pre-Co-Inoculation with Trichoderma Species and Subsequent Pathogen Challenge
3. Discussion
4. Materials and Methods
4.1. Plant Materials and Growth Conditions
4.2. Trichoderma Growth and Inoculum Preparation
4.3. In Vitro Growth Assays of Arabidopsis 35S::TaEPL1-3 and WT Lines During Interaction with Trichoderma virens and Trichoderma atroviride
4.4. Pathogen Inoculum Preparation
4.5. Determination of Pseudomonas syringae CFU in Arabidopsis 35S::TaEPL1-3 and Col-0 Plants Pre-Inoculated with Trichoderma Species
4.6. Quantification of Botrytis cinerea Lesion Size in Arabidopsis 35S::TaEPL1-3 and Col-0 Plants Pre-Treated with Trichoderma Species
4.7. Determination of Hydrogen Peroxide Content Using Potassium Iodide (KI) in Arabidopsis 35S::TaEPL1-3 and Col-0
4.8. Statistical Analysis
5. Conclusions
Author Contributions
Funding
Data Availability Statement
Conflicts of Interest
References
- Delaux, P.M.; Schornack, S. Plant evolution driven by interactions with symbiotic and pathogenic microbes. Science 2021, 371, 6531. [Google Scholar] [CrossRef] [PubMed]
- Oldroyd, G. Speak, friend, and enter: Signalling systems that promote beneficial symbiotic associations in plants. Nat. Rev. Microbiol. 2013, 11, 252–263. [Google Scholar] [CrossRef]
- Müller, D.B.; Vogel, C.; Bai, Y.; Vorholt, J.A. The plant microbiota: Systems-level insights and perspectives. Annu. Rev. Genet. 2016, 50, 211–234. [Google Scholar] [CrossRef] [PubMed]
- Delgado-Sánchez, P.; Jiménez-Bremont, J.F.; Guerrero-González, M.L.; Joel, F. Effect of fungi and light on seed germination of three Opuntia species from semiarid lands of central Mexico. J. Plant Res. 2013, 126, 643–649. [Google Scholar] [CrossRef]
- Dutta, P.; Mahanta, M.; Singh, S.B.; Thakuria, D.; Deb, L.; Kumari, A.; Upamanya, G.K.; Boruah, S.; Dey, U.; Mishra, A.K. Molecular interaction between plants and Trichoderma species against soil-borne plant pathogens. Front. Plant Sci. 2023, 14, 1145715. [Google Scholar] [CrossRef]
- Woo, S.L.; Hermosa, R.; Lorito, M.; Monte, E. Trichoderma: A multipurpose, plant-beneficial microorganism for eco-sustainable agriculture. Nat. Rev. Microbiol. 2023, 21, 312–326. [Google Scholar] [CrossRef]
- González-Pérez, E.; Ortega-Amaro, M.A.; Salazar-Badillo, F.B.; Bautista, E.; Douterlungne, D.; Jiménez-Bremont, J.F. The Arabidopsis-Trichoderma interaction reveals that the fungal growth medium is an important factor in plant growth induction. Sci. Rep. 2018, 8, 1–14. [Google Scholar] [CrossRef]
- Nieto-Jacobo, M.F.; Steyaert, J.M.; Salazar-Badillo, F.B.; Nguyen, D.V.; Rostás, M.; Braithwaite, M.; De Souza, J.T.; Jimenez-Bremont, J.F.; Ohkura, M.; Stewart, A.; et al. Environmental growth conditions of Trichoderma spp. affects indole acetic acid derivatives, volatile organic compounds, and plant growth promotion. Front. Plant Sci. 2017, 8, 102. [Google Scholar] [CrossRef] [PubMed]
- Ramírez-Valdespino, C.A.; Casas-Flores, S.; Olmedo-Monfil, V. Trichoderma as a model to study effector-like molecules. Front. Microbiol. 2019, 10, 1030. [Google Scholar] [CrossRef]
- Rojas-Moreno, M.M.; González-Pérez, E.; Rodríguez-Hernandez, A.A.; Ortega-Amaro, M.A.; Becerra-Flora, A.; Serrano, M.; Jiménez-Bremont, J.F. Expression of EPL1 from Trichoderma atroviride in Arabidopsis confers resistance to bacterial and fungal pathogens. Plants 2023, 12, 2443. [Google Scholar] [CrossRef]
- Jiménez-Bremont, J.F.; González-Pérez, E.; Ortega-Amaro, M.A.; Madrigal-Ortiz, S.; Duque-Ortiz, A.; Mendoza-Mendoza, A. Volatile organic compounds emitted by Trichoderma: Small molecules with biotechnological potential. Sci. Hortic. 2024, 325, 112656. [Google Scholar] [CrossRef]
- Djonović, S.; Pozo, M.J.; Dangott, L.J.; Howell, C.R.; Kenerley, C.M. Sm1, a proteinaceous elicitor secreted by the biocontrol fungus Trichoderma virens induces plant defense responses and systemic resistance. Mol. Plant-Microbe Interact. 2006, 19, 838–853. [Google Scholar] [CrossRef]
- Luti, S.; Sella, L.; Quarantin, A.; Pazzagli, L.; Baccelli, I. Twenty years of research on cerato-platanin family proteins: Clues, conclusions, and unsolved issues. Fungal Biol. Rev. 2020, 34, 13–24. [Google Scholar] [CrossRef]
- Frischmann, A.; Neudl, S.; Gaderer, R.; Bonazza, K.; Zach, S.; Gruber, S.; Spadiut, O.; Friedbacher, G.; Grothe, H.; Seidl-Seiboth, V. Self-assembly at air/water interfaces and carbohydrate binding properties of the small secreted protein EPL1 from the fungus Trichoderma atroviride. J. Biol. Chem. 2013, 288, 4278–4287. [Google Scholar] [CrossRef]
- Pazzagli, L.; Seidl-Seiboth, V.; Barsottini, M.; Vargas, W.A.; Scala, A.; Mukherjee, P.K. Cerato-platanins: Elicitors and effectors. Plant Sci. 2014, 228, 79–87. [Google Scholar] [CrossRef]
- Baccelli, I. Cerato-platanin family proteins: One function for multiple biological roles? Front. Plant Sci. 2015, 5, 2013–2016. [Google Scholar] [CrossRef]
- Samolski, I.; de Luis, A.; Vizcaíno, J.A.; Monte, E.; Suárez, M.B. Gene expression analysis of the biocontrol fungus Trichoderma harzianum in the presence of tomato plants, chitin, or glucose using a high-density oligonucleotide microarray. BMC Microbiol. 2009, 9, 217. [Google Scholar] [CrossRef] [PubMed]
- Jeong, J.S.; Mitchell, T.K.; Dean, R.A. The Magnaporthe grisea snodprot1 homolog, MSP1, is required for virulence. FEMS Microbiol. Lett. 2007, 273, 157–165. [Google Scholar] [CrossRef] [PubMed]
- Frías, M.; González, C.; Brito, N. BcSpl1, a cerato-platanin family protein, contributes to Botrytis cinerea virulence and elicits the hypersensitive response in the host. New Phytologist. 2011, 192, 483–495. [Google Scholar] [CrossRef] [PubMed]
- Seidl, V.; Marchetti, M.; Schandl, R.; Allmaier, G.; Kubicek, C.P. Epl1, the major secreted protein of Hypocrea atroviridis on glucose, is a member of a strongly conserved protein family comprising plant defense response elicitors. FEBS J. 2006, 273, 4346–4359. [Google Scholar] [CrossRef]
- Vargas, W.A.; Djonović, S.; Sukno, S.A.; Kenerley, C.M. Dimerization controls the activity of fungal elicitors that trigger systemic resistance in plants. J. Biol. Chem. 2008, 283, 19804–19815. [Google Scholar] [CrossRef]
- Salas-Marina, M.A.; Isordia-Jasso, M.I.; Islas-Osuna, M.A.; Delgado-Sánchez, P.; Bremont, J.F.J.; Rodríguez-Kessler, M.; Rosales-Saavedra, M.T.; Herrera-Estrella, A.; Casas-Flores, S. The Epl1 and Sm1 proteins from Trichoderma atroviride and Trichoderma virens differentially modulate systemic disease resistance against different life style pathogens in Solanum lycopersicum. Front. Plant Sci. 2015, 6, 77. [Google Scholar] [CrossRef] [PubMed]
- Mendoza-Mendoza, A.; Rinat, Z.; Robert, L.; Rosa, H.; Enrique, M.; Benjamin, A.H.; Prasun, K. Mukherjee Molecular dialogues between Trichoderma and roots: Role of the fungal secretome. Fungal Biol. Rev. 2018, 32, 62–85. [Google Scholar] [CrossRef]
- Gomes, E.; Costa, M.; de Paula, R.; de Azevedo, R.R.; da Silva, F.L.; Noronha, E.F.; Ulhoa, C.J.; Monteiro, V.N.; Cardoza, R.E.; Gutiérrez, S.; et al. The Cerato-Platanin protein Epl-1 from Trichoderma harzianum is involved in mycoparasitism, plant resistance induction and self cell wall protection. Sci. Rep. 2016, 5, 17998. [Google Scholar] [CrossRef]
- Ashwin, N.M.R.; Amalamol, D.; Lakshana, K.V.; Remya, M.; Ramesh Sundar, A.; Malathi, P.; Viswanathan, R. Role of Cerato-Platanins in inducing PAMP-triggered immunity in plants. In Microbial Biocontrol: Molecular Perspective in Plant Disease Management; Bastas, K.K., Kumar, A., Sivakumar, U., Eds.; Springer Nature: Singapore, 2023; pp. 29–59. [Google Scholar] [CrossRef]
- Contreras-Cornejo, H.A.; Macías-Rodríguez, L.; Beltrán-Peña, E.; Herrera-Estrella, A.; López-Bucio, J. Trichoderma-induced plant immunity likely involves both hormonal-and camalexin-dependent mechanisms in Arabidopsis thaliana and confers resistance against necrotrophic fungi Botrytis cinerea. Plant Signal. Behav. 2011, 6, 1554–1563. [Google Scholar] [CrossRef] [PubMed]
- Buensanteai, N.; Mukherjee, P.K.; Horwitz, B.A.; Cheng, C.; Dangott, L.J.; Kenerley, C.M. Expression and purification of biologically active Trichoderma virens proteinaceous elicitor Sm1 in Pichia pastoris. Protein Expr. Purif. 2010, 72, 131–138. [Google Scholar] [CrossRef] [PubMed]
- Sharma, P.; Jambhulkar, P.P.; Raja, M.; Sain, S.K.; Javeria, S. Trichoderma spp. in consortium and their rhizospheric interactions. In Trichoderma. Rhizosphere Biology; Sharma, A., Sharma, P., Eds.; Springer: Singapore, 2020; pp. 267–292. [Google Scholar] [CrossRef]
- Dubey, S.C.; Tripathi, A.; Singh, B. Integrated management of Fusarium wilt by combined soil application and seed dressing formulations of Trichoderma species to increase grain yield of chickpea. Int. J. Pest. Manag. 2013, 59, 47–54. [Google Scholar] [CrossRef]
- Baccelli, I.; Lombardi, L.; Luti, S.; Bernardi, R.; Picciarelli, P.; Scala, A.; Pazzagli, L. Cerato-platanin induces resistance in Arabidopsis leaves through stomatal perception, overexpression of salicylic acid- and ethylene-signalling genes and camalexin biosynthesis. PLoS ONE 2014, 9, e100959. [Google Scholar] [CrossRef]
- Lombardi, L.; Faoro, F.; Luti, S.; Baccelli, I.; Martellini, F.; Bernardi, R.; Picciarelli, P.; Scala, A.; Pazzagli, L. Differential timing of defense-related responses induced by cerato-platanin and cerato-populin, two non-catalytic fungal elicitors. Physiol. Plant. 2013, 149, 408–421. [Google Scholar] [CrossRef]
- Yang, Y.; Zhang, H.; Li, G.; Li, W.; Wang, X.; Song, F. Ectopic expression of MgSM1, a Cerato-platanin family protein from Magnaporthe grisea, confers broad-spectrum disease resistance in Arabidopsis. Plant Biotechnol. J. 2009, 7, 763–777. [Google Scholar] [CrossRef]
- Katagiri, F.; Thilmony, R.; He, S.Y. The Arabidopsis thaliana-Pseudomonas syringae Interaction. Arab. Book 2002, 1, e0039. [Google Scholar] [CrossRef] [PubMed]
- Aragón, W.; Formey, D.; Aviles-Baltazar, N.Y.; Torres, M.; Serrano, M. Arabidopsis thaliana cuticle composition contributes to differential defense response to Botrytis cinerea. Front. Plant Sci. 2021, 5, 12. [Google Scholar] [CrossRef] [PubMed]
- Junglee, S.; Urban, L.; Sallanon, H.; Lopez-Lauri, F. Optimized Assay for Hydrogen Peroxide Determination in Plant Tissue Using Potassium Iodide. Am. J. Anal. Chem. 2014, 5, 730–736. [Google Scholar] [CrossRef]

Disclaimer/Publisher’s Note: The statements, opinions and data contained in all publications are solely those of the individual author(s) and contributor(s) and not of MDPI and/or the editor(s). MDPI and/or the editor(s) disclaim responsibility for any injury to people or property resulting from any ideas, methods, instructions or products referred to in the content. |
© 2025 by the authors. Licensee MDPI, Basel, Switzerland. This article is an open access article distributed under the terms and conditions of the Creative Commons Attribution (CC BY) license (https://creativecommons.org/licenses/by/4.0/).
Share and Cite
Astorga-Arzola, E.T.; González-Pérez, E.; Becerra Flora, A.; Jiménez-Bremont, J.F. Inoculation with Trichoderma atroviride and T. virens Induces ROS Overaccumulation and Compromises Pathogen Resistance in Arabidopsis 35S::TaEPL1-3 Plants. Plants 2025, 14, 2794. https://doi.org/10.3390/plants14172794
Astorga-Arzola ET, González-Pérez E, Becerra Flora A, Jiménez-Bremont JF. Inoculation with Trichoderma atroviride and T. virens Induces ROS Overaccumulation and Compromises Pathogen Resistance in Arabidopsis 35S::TaEPL1-3 Plants. Plants. 2025; 14(17):2794. https://doi.org/10.3390/plants14172794
Chicago/Turabian StyleAstorga-Arzola, Ever Trinidad, Enrique González-Pérez, Alicia Becerra Flora, and Juan Francisco Jiménez-Bremont. 2025. "Inoculation with Trichoderma atroviride and T. virens Induces ROS Overaccumulation and Compromises Pathogen Resistance in Arabidopsis 35S::TaEPL1-3 Plants" Plants 14, no. 17: 2794. https://doi.org/10.3390/plants14172794
APA StyleAstorga-Arzola, E. T., González-Pérez, E., Becerra Flora, A., & Jiménez-Bremont, J. F. (2025). Inoculation with Trichoderma atroviride and T. virens Induces ROS Overaccumulation and Compromises Pathogen Resistance in Arabidopsis 35S::TaEPL1-3 Plants. Plants, 14(17), 2794. https://doi.org/10.3390/plants14172794

